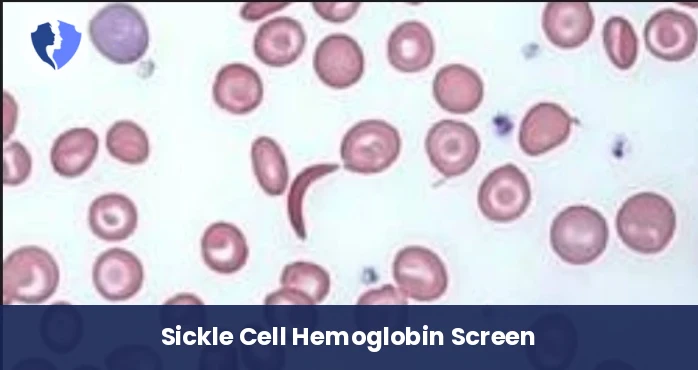
Sickle Cell Screen Test

Service Details
Sickle Cell Screen Test
A qualitative (non-quantitative) screening test detects the presence of sickle cell hemoglobin (HbS) in the blood. The most common methods (such as the Sickledex solubility test or the Sickling test) rely on the unique chemical property of HbS, which becomes insoluble and clumps under low-oxygen conditions, causing a visible change in the sample. It is used as a preliminary test, and a positive result requires confirmation by hemoglobin electrophoresis.